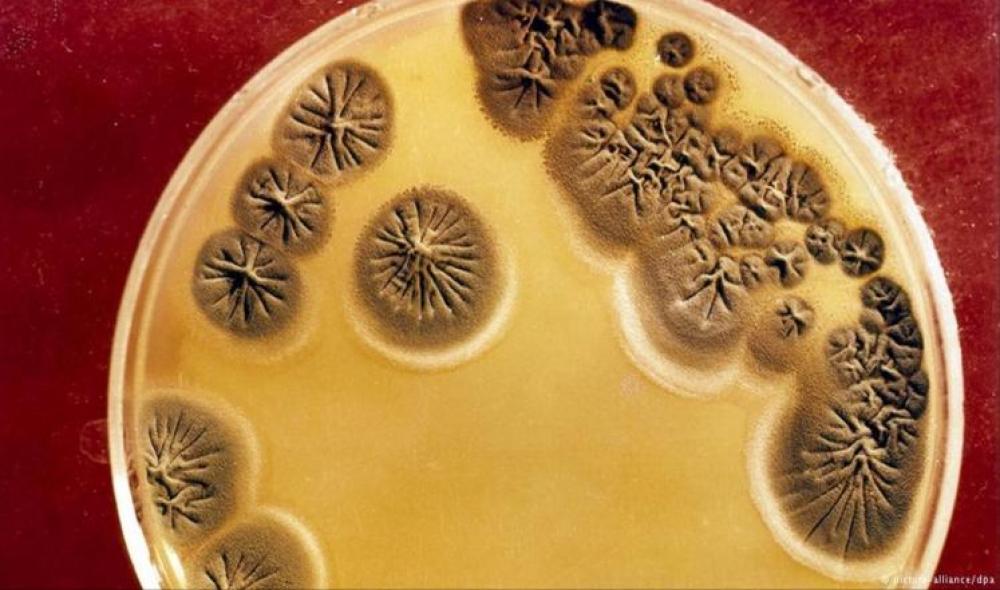
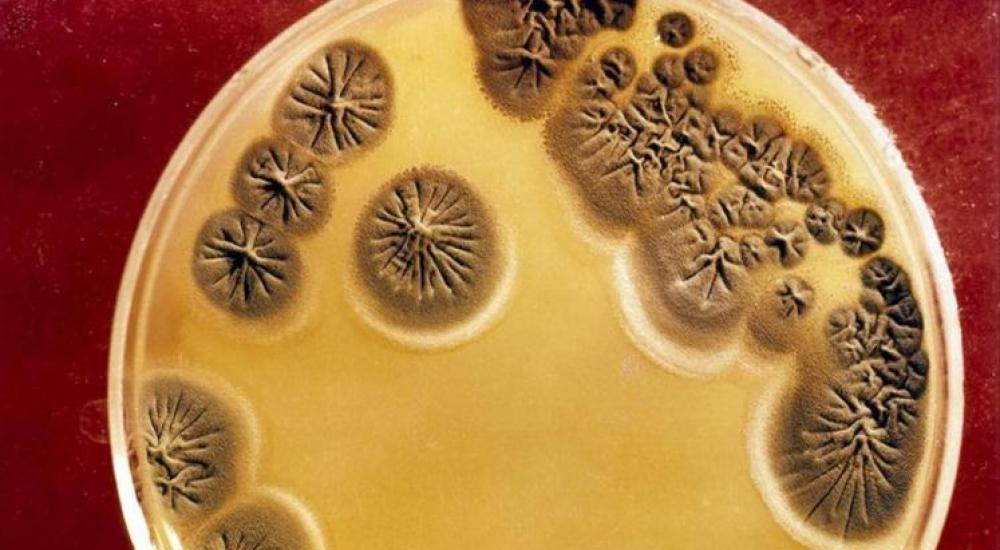

قالت المراكز الأميركية لمكافحة الأمراض والوقاية منها إنه تم اكتشاف بكتيريا جديدة تسبب داء "لايم" للإنسان والذي تنقله حشرات القراد والحلم.
وقالت المراكز -في بيان يوم الاثنين الماضي- إنها تعاونت مع مؤسسة "مايو كلينيك" ومسؤولي الصحة في ويسكونسن وداكوتا الشمالية في اكتشاف البكتيريا الجديدة واسمها العلمي "بوريليا مايوناي".
وأضافت المراكز أنه كان معروفا في السابق أن نوعا واحدا من البكتيريا اسمه العلمي "بوريليا بورغودورفيري" هو المسبب لمرض "لايم" الذي ينقله القراد في نصف الكرة الأرضية الشمالي.
وتبدأ أعراض المرض بالحمى وآلام الرأس والإرهاق والطفح الجلدي المنتشر، وإذا لم يتلق المصاب العلاج اللازم بالمضادات الحيوية، تتطور الحالة لتشمل أعراضا تصيب القلب والمفاصل والجهاز العصبي.
وقالت المراكز إن الباحثين اكتشفوا البكتيريا الجديدة بعد فحص عينات دم من مرضى في ويسكونسن وداكوتا الشمالية ممن يعتقد بإصابتهم بداء لايم خلال الفترة بين عامي 2012 و2014.
وأضافت أن عينات من ستة مرضى من أصل تسعة آلاف مريض أظهرت نتائج استثنائية، مما استدعى إجراء مزيد من الدراسة.
وتتشابه أعراض البكتيريا الجديدة "بوريليا مايوناي" مع القديمة "بوريليا بورغودورفيري"، لكن الأولى تتسم بأعراض إضافية منها الشعور بالغثيان والقيء مع انتشار البكتيريا بكثافة في الدم.
وقالت المراكز إن نحو 300 ألف شخص يصابون بداء لايم في الولايات المتحدة سنويا، وقلما يفضي المرض إلى الوفاة، ويتعافى المرضى منه في غضون بضعة أسابيع بعد تناول المضادات الحيوية عن طريق الفم.
وأضافت أن المصابين بالبكتيريا الجديدة تعافوا بعد تعاطي نفس المضادات الحيوية لعلاج الإصابة بالبكتيريا القديمة، لكن من السابق لأوانه القول إن البكتيريا الجديدة أكثر أو أقل خطورة من الأخرى.
ويقول الباحثون إن أصنافا من القراد الأسود الأرجل -ومنها قراد الأيائل الذي ينتشر في المساكن الخشبية والمناطق العشبية- تحمل البكتيريا القديمة التي توجد في 45% من المقاطعات الأميركية، بينما كانت هذه النسبة 30% فقط عام 1998.
وينتشر قراد الأيائل الآن في 842 مقاطعة في 35 ولاية أميركية تتركز في شمال شرق البلاد، لكن العدوى انتقلت غربا وجنوبا. وتقول منظمة الصحة العالمية إن القراد الأميركي ينشر المرض أيضا في آسيا وشمال غرب أوروبا ووسطها وشرقها.